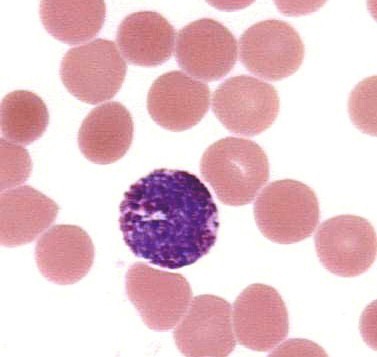

A basophil is characterized by a lobed nucleus and it is filled by large blue-black granules that sometimes cover the nucleus. Here you can see the distinct granules against the purple nucleus. Can you find platelets on this photo?

http://microanatomy.net/blood/basophils.htm
Gwen V. Childs, Ph.D., FAAA
Department of Neurobiology and Developmental Sciences
University of Arkansas for Medical Sciences
4301 W. Markham, Slot 510, Little Rock, AR 72205
For questions or concerns, send email to this address


